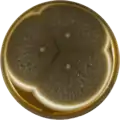
Aspergillus vadensis growing on MEAOX plate

| Aspergillus vadensis | |
|---|---|
| Scientific classification | |
| Domain: | Eukaryota |
| Kingdom: | Fungi |
| Division: | Ascomycota |
| Class: | Eurotiomycetes |
| Order: | Eurotiales |
| Family: | Aspergillaceae |
| Genus: | Aspergillus |
| Species: | A. vadensis |
| Binomial name | |
| Aspergillus vadensis de Vries et al. 2007[1] | |
Aspergillus vadensis is a species of fungus in the genus Aspergillus. It belongs to the group of black Aspergilli which are important industrial workhorses.[2][3][4] A. vadensis belongs to the Nigri section. The species was first described in 2004.[1] It has been found in air in Egypt. It produces the secondary metabolites asperazine and aurasperone A.
The genome of A. vadensis was sequenced and published in 2014 as part of the Aspergillus whole-genome sequencing project – a project dedicated to performing whole-genome sequencing of all members of the genus Aspergillus.[5] The genome assembly size was 35.66 Mbp.[5]
Growth and morphology
A. vadensis has been cultivated on both Czapek yeast extract agar (CYA) plates and Malt Extract Agar Oxoid (MEAOX) plates. The growth morphology of the colonies can be seen in the pictures below.
 Aspergillus vadensis growing on CYA plate
Aspergillus vadensis growing on CYA plate Aspergillus vadensis growing on MEAOX plate
Aspergillus vadensis growing on MEAOX plate
References
- 1 2 de Vries, R. P.; Frisvad, J. C.; van de Vondervoort, P. J. I.; Burgers, K.; Kuijpers, A. F. A.; Samson, R. A.; Visser, J. Aspergillus vadensis, a new species of the group of black Aspergilli. Antonie van Leeuwenhoek 2005, 87, 195–203, doi:10.1007/s10482-004-3194-y.
- ↑ Pel, H. J.; de Winde, J. H.; Archer, D. B.; Dyer, P. S.; Hofmann, G.; Schaap, P. J.; Turner, G.; de Vries, R. P.; Albang, R.; Albermann, K.; Andersen, M. R.; Bendtsen, J. D.; Benen, J. A. E.; van den Berg, M.; Breestraat, S.; Caddick, M. X.; Contreras, R.; Cornell, M.; Coutinho, P. M.; Danchin, E. G. J.; Debets, A. J. M.; Dekker, P.; van Dijck, P. W. M.; van Dijk, A.; Dijkhuizen, L.; Driessen, A. J. M.; d’Enfert, C.; Geysens, S.; Goosen, C.; Groot, G. S. P.; de Groot, P. W. J.; Guillemette, T.; Henrissat, B.; Herweijer, M.; van den Hombergh, J. P. T. W.; van den Hondel, C. A. M. J. J.; van der Heijden, R. T. J. M.; van der Kaaij, R. M.; Klis, F. M.; Kools, H. J.; Kubicek, C. P.; van Kuyk, P. A.; Lauber, J.; Lu, X.; van der Maarel, M. J. E. C.; Meulenberg, R.; Menke, H.; Mortimer, M. A.; Nielsen, J.; Oliver, S. G.; Olsthoorn, M.; Pal, K.; van Peij, N. N. M. E.; Ram, A. F. J.; Rinas, U.; Roubos, J. A.; Sagt, C. M. J.; Schmoll, M.; Sun, J.; Ussery, D.; Varga, J.; Vervecken, W.; van de Vondervoort, P. J. J.; Wedler, H.; Wösten, H. A. B.; Zeng, A.-P.; van Ooyen, A. J. J.; Visser, J.; Stam, H. Genome sequencing and analysis of the versatile cell factory Aspergillus niger CBS 513.88. Nat. Biotechnol. 2007, 25, 221–231, doi:10.1038/nbt1282.
- ↑ Goldberg, I.; Rokem, J. S.; Pines, O. Organic acids: old metabolites, new themes. Journal of Chemical Technology & Biotechnology 2006, 81, 1601–1611, doi:10.1002/jctb.1590.
- ↑ Pariza, M. W.; Foster, E. M. Determining the Safety of Enzymes Used in Food Processing. Journal of Food Protection 1983, 46, 453–468, doi:10.4315/0362-028X-46.5.453.
- 1 2 "Home - Aspergillus vadensis CBS 113365 v1.0". Genome.jgi.doe.gov. Retrieved 2 May 2022.
Further reading
- De Vries, Ronald P.; et al. (2004). "A new black Aspergillus species, A. vadensis, is a promising host for homologous and heterologous protein production". Applied and Environmental Microbiology. 70 (7): 3954–3959. Bibcode:2004ApEnM..70.3954D. CiteSeerX 10.1.1.318.7360. doi:10.1128/aem.70.7.3954-3959.2004. PMC 444756. PMID 15240269.
- Samson, Robert A.; et al. (2004). "New ochratoxin A or sclerotium producing species in Aspergillus section Nigri". Stud Mycol. 50: 45–61.
- Alberto, F.; et al. (2009). "Technical advance in fungal biotechnology: development of a miniaturized culture method and an automated high‐throughput screening". Letters in Applied Microbiology. 49 (2): 278–282. doi:10.1111/j.1472-765x.2009.02655.x. PMID 19486280. S2CID 32305325.
- Geiser, D. M.; et al. (2007). "The current status of species recognition and identification in Aspergillus". Studies in Mycology. 59: 1–10. doi:10.3114/sim.2007.59.01. PMC 2275194. PMID 18490947.